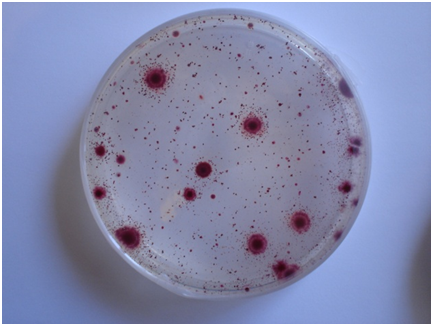

BACILLUS SPOROTHERMODURANS CROMOKIT AGAR (HRS CROMOGENIC AGAR)
BACILLUS SPOROTHERMODURANS CROMOKIT AGAR (HRS CROMOGENIC AGAR) es el agar que permite detectar y contar las esporas resistentes a la UHT
INTRODUCCIÓN
La presencia de esporas altamente resistentes al calor de Bacillus sporothermodurans en leche pasterizada por el método Ultra Hight Temperature (UHT) se ha convertido en un problema importante en la industria láctea.
Su presencia se considera indeseable, ya que obstaculizan los requisitos de esterilidad comercial.
En un estudio (APPLIED AND ENVIRONMENTAL MICROBIOLOGY, Mar. 2005, p. 1480–1494), se han evaluado, mediante el uso de un selectivo tratamiento térmico de 30 minutos a 100°C, la presencia, fuentes, y naturaleza de las esporas potencialmente muy resistentes al calor en la leche cruda.
Se detectaron altos números de estas esporas en la tela del filtro del equipo de ordeño y en muestras de cultivos y forrajes verdes.
Se aislaron aproximadamente 700 cepas después del calentamiento selectivo. La colección de cepas mostró una notable diversidad, con representantes de siete géneros que forman esporas aerobias.
Las más frecuentes esporas aisladas de leche UHT han sido Bacillus sporothermodurans, Paenibacillus lactis, Brevibacillus borstelensis, Bacillus sphaericus, Bacillus licheniformis, y Brevibacillus brevis.
El 23% de las 603 cepas formadoras de esporas pertenecen a 18 nuevas especies.
La reducción de esta carga de esporas por buenas medidas higiénicas durante el ordeño probablemente podría reducir aún más el nivel de contaminación de la leche cruda, y de esta manera reducir al mínimo el recuento aeróbico de formadores de esporas de bacterias que podrían conducir al deterioro de la leche y los productos lácteos.
Las HRS (Heat Resistant Spores)
o más coloquialmente “termorresistentes”, aparecen en muestras de leche UHT, sobre todo si el método de tratamiento térmico es “indirecto” (intercambiador de calor).
Los métodos “directos” con inyección de vapor sobrecalentado son más eficaces, pero estas esporas también aparecen de vez en cuando.
No son un problema para la salud y aparentemente no alteran la leche, de modo que nos hemos acostumbrado a beber leche contaminada por estos microorganismos.
El problema no es para el consumidor sino para la imagen de la industria.
MICROKIT ha desarrollado un medio de cultivo cromogénico, derivado del Plate Count Agar ISO 4833, con factores “doping” que permiten la visión de estas esporas germinadas en forma de colonias, que suelen ser diminutas y rojas, gracias a un cromógeno termoestable.
El medio no es selectivo para B. sporothermodurans, de modo que también crecen en el mismo Bacillus licheniformis, Bacillus sphaericus y los demás esporulados alterativos de la leche UHT:
las esporas termorresistentes (HRS). Pero se denomina así por el mayor conocimiento que tiene la industria láctea de la denominación “B. sporothermodurans” que de las siglas HRS.
COMPOSICIÓN
- Triptona 5,0 g
- Extracto de Levadura 2,5 g
- Glucosa 1,0 g
- Factores doping MICROKIT 8,0 g
- Agar‑agar 10,5 g
- Cromógeno termoestable c.s.
- (Fórmula por litro)
- pH final: 6,8 ± 0,2
PREPARACIÓN
Disolver 27 g de medio en 1 litro de agua destilada.
Calentar hasta ebullición, agitando para su completa disolución.
Repartir en tubos o frascos. Autoclavar a 121 ºC durante 15 min o preferiblemente a 116°C durante 15 minutos. No sobrecalentar ni mantener fundido mucho tiempo. Refundir sólo una vez. El color final del medio es blanco-crema. A veces, por sobrecalentamiento, adquiere un tono rosado que retorna al crema cuando se vuelve a enfriar el medio, lo cual no afecta los resultados.
PARA USO EXCLUSIVO EN LABORATORIO.
MANTENGA EL BOTE BIEN CERRADO EN LUGAR SECO, FRESCO Y OSCURO. AGITE EL BOTE ANTES DE USAR.
DESHIDRATADO CODIGO: DMT532
CONTROL DE CALIDAD DEL MEDIO
Realizado en nuestro laboratorio; es prudente repetirlo en su laboratorio siempre que varíen las condiciones (más de 3 meses sin usar, tras desinfectar laboratorio, tras conservar a alta Tª, cuando adquiere aspectos extraños aunque no haya llegado la fecha de caducidad teórica de la etiqueta,…). DESHIDRATADO: Polvo grueso, Crema PREPARADO: Estéril, Crema
EVALUACIÓN DEL RENDIMIENTO ISO/TS 11133-2 24-48 h a 37 ºC o mejor 72 h a 30 ºC, aplicando el método ISO 4833, ISO 2293, o el indicado en el Manual MICROKIT:
- Bacillus subtilis WDCM 00003, Excelente, colonias rojas, PR >90% de colonias respecto al número de ufc certificadas e inoculadas en TSA.
- Bacillus simplex ssp.roloensis CCCNT 0010, Excelente, colonias rojas, PR >90% de colonias respecto al número de ufc certificadas e inoculadas en TSA.
- Bacillus pumilus‐cali CCCNT 0020, Excelente, colonias rojas, PR >90% de colonias respecto al número de ufc certificadas e inoculadas en TSA.
- Bacillus cereus-aerius CCCNT 0001, Excelente, colonias rojas, PR >90% de colonias respecto al número de ufc certificadas e inoculadas en TSA.
Las colecciones TIPO prohíben el uso de su referencia, por lo que indicamos la Universal WDCM según ISO 11133-2:2014 y la Colección de Cepas Nativas Tropicales.
PRESENTACIÓN: MEDIO DESHIDRATADO (100 g, 500 g, 5 Kg).
Recuento total de bacterias esporuladas en leche UHT y otros alimentos (lácteos, gelatina, forraje…). Las colonias crecen en distintos tonos del rojo: rosa, naranja, púrpura…. sobre el tono crema del medio (excepto ciertos acidolácticos y ciertas levaduras, que crecen con colonias blancas, sin viraje, por lo que este medio los distingue de los aerobios). El color no afecta a las pruebas de identificación posteriores que quisiera realizar.
MODO DE EMPLEO E INTERPRETACIÓN DE RESULTADOS
Inocular 1 ml de muestra de leche y su serie de diluciones decimales, en masa. Incubar una placa a 30 ºC aproximadamente durante 48 horas, e incubar otra placa a 55 ºC aproximadamente durante 48 horas. Contar todas las colonias. La recuperación supera el 20% por encima de la obtenida en PCA y el 16% por encima de la obtenida en TSA, gracias a ciertos factores doping de aerobios descubiertos y agregados por MICROKIT. Esta fórmula, con menos agar, aumenta la sensibilidad del medio frente a los aerobios más lábiles, al permitir una mejor oxigenación del fondo. Este medio está diseñado para siembra en masa. Si desea sembrar en superficie, utilice 32 g/l de este mismo medio, en lugar de 27 g/l. Para minimizar la desecación en muestreos de aire y superficies, o para siembra en Spiral, añadir 2 gotas de antiburbujas (SBL001) por cada litro de agua, antes de añadir el medio y antes de autoclavar.
El usuario es el único responsable de la eliminación de los microorganismos según la legislación medioambiental vigente. Autoclavar antes de desechar a la basura.
Si desea más información sobre nuestros BACILLUS SPOROTHERMODURANS CROMOKIT AGAR (HRS CROMOGENIC AGAR) rellene nuestro formulario de contacto http://www.medioscultivo.com/contacto . O si lo prefiere póngase en contacto con nosotros a través de nuestro correo electrónico microkit@microkit.es o por teléfono en el nº 91-897 46 16
https://www.microkit.es/fichas/HRS-RAPID-Cromogenic-sporothermodurans-Agar.pdf
https://www.microkit.es/monograficos/10-Bacillus-monograf–a.pdf
Prepárese para más de una sorpresa informativa cuando vea nuestro video sobre los medios Cromogénicos: https://www.youtube.com/watch?v=-JVPVWxY8ZE&t=271s

Hola, necesito información como adquirir este medio de cultivo en Ecuador